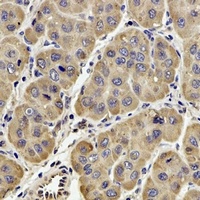
产品细节图片2

相关产品推荐更多 >
万千商家帮你免费找货
0 人在求购买到急需产品
- 详细信息
- 文献和实验
- 技术资料
- 抗体名:
GPx-4 Antibody抗体
- 抗体英文名:
GPx-4 Antibody
- 应用范围:
IF, IHC, WB
- 宿主:
Rabbit
- 适应物种:
Human, Mouse, Rat
- 保质期:
6-12个月
- 抗原来源:
详询
- 目录编号:
orb340797
- 级别:
科研级
- 库存:
88
- 供应商:
biorbyt
- 标记物:
Unconjugated
- 克隆性:
Polyclonal
- 形态:
Liquid in 0.42% Potassium phosphate, 0.87% Sodium chloride, pH 7.3, 30% glycerol, and 0.01% sodium azide.
- 免疫原:
Recombinant fusion protein of human GPx-4
- 规格:
30 ul
别名:Phospholipid hydroperoxide glutathione peroxidase mitochondrial; PHGPx; Glutathione peroxidase 4; GPx-4; GSHPx-4
免疫原:Recombinant fusion protein of human GPx-4
应用稀释比例:WB: 1:500-1:2000, IHC-P: 1:50-1:200, IF/ICC: 1:10-1:100
纯化:The antibody was purified by immunogen affinity chromatography.
保存说明:Maintain refrigerated at 2-8°C for up to 2 weeks. For long term storage store at -20°C in small aliquots to prevent freeze-thaw cycles.
Pubmed:39698827, 36035224, 35244190
Entrez:2879
UniProt ID:P36969
Note:For research use only.

风险提示:丁香通仅作为第三方平台,为商家信息发布提供平台空间。用户咨询产品时请注意保护个人信息及财产安全,合理判断,谨慎选购商品,商家和用户对交易行为负责。对于医疗器械类产品,请先查证核实企业经营资质和医疗器械产品注册证情况。
文献和实验一、使用范围GPX-150光照培养箱是具有光照功能的高精度冷热恒温设备。可用于植物的发芽、组织、育苗、微生物的培养、昆虫、小玻璃的饲养,水质监测的BOD测定,以及其他用途恒温试验,是生物遗传工程、医药、农业、林业、玻璃科学、畜牧、水产等生产、科研、教学部门较为理想的试验设备。二、结构特点本光照培养箱内左右内侧装有相应功率的日光灯,在外门及两侧镶有保温性和透光性良好的特种玻璃,以减少日光灯入射的热量传入,既满足了室内样品所需光照度,同时也便于观察箱内样品的变化。温度控制采用集成运放线路,附有
chain reaction (RT-PCR) assay to investigate the effect of incubation of freshly isolated rat cardiomyocytes for 2 h at 37�C with or without 0.5 mM cysteine on the expression of cellular glutathione peroxidase (GPx1). The main analytical
重大突破!甘波谊团队 Nature 首次报道第三种铁死亡抑制机制,提供抗癌新思路
细胞死亡与癌症等疾病有着密切关系,在细胞的各式花样死法中,铁死亡(ferroptosis)作为一种新兴的死亡方式,近年来越来越受到大家的关注。图片来源:站酷海洛 Plus铁死亡是一种由脂质过氧化引起的细胞死亡方式,是抑制肿瘤生长的关键机制之一。先前的研究发现细胞至少进化出两种防御机制来抑制铁死亡的发生:1) 谷胱甘肽过氧化物酶 4(GPX4)利用还原性谷胱甘肽(GSH)消除脂质过氧化物并抑制铁死亡;2) FSP1(也称为 AIFM2)作为一种氧化还原酶,主要在质膜上将 CoQ 还原
技术资料暂无技术资料 索取技术资料










